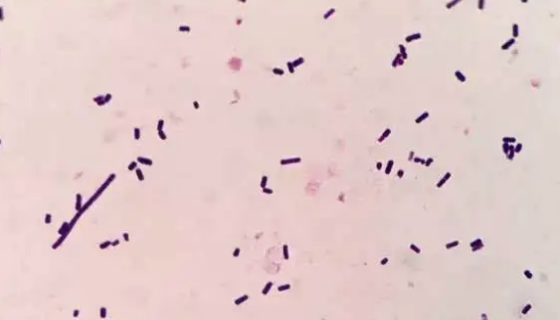
荚膜红细菌的培养条件与注意事项及打管说明！

ZJ46植物乳杆菌植物亚种冻干管打管说明书!
植物乳杆菌植物亚种,与酵母联合发酵面制品,改善其风味。主要用...

冠突散囊菌的培养条件与注意事项及打管说明!
冠突散囊菌俗称“金花”, 属于散囊菌目发菌科散囊菌属的一种真...

小鼠小脑细胞的制备方法与培养操作步骤!
小脑是中枢神经系统中最大的运动器官中枢,主要作用是维持躯体平...

ATCC 27715 猪肺炎支原体 百欧博伟生物
猪肺炎支原体,是由猪肺炎支原体引发的一种慢性肺炎,又称猪地方...

ATCC 9120 肠沙门氏菌肠炎亚种菌株说明!
肠沙门氏菌肠亚种是Salmonella属的微生物,原产地为中...

生孢梭菌的性质与用途及生产工艺!
生孢梭菌(Clostridium sporogenes)又译...

Humanpodocyte人肾足细胞的处理方法与培养步骤!
肾足细胞即肾小球上皮细胞,它附着于肾小球基底膜的外侧,连同肾...
荚膜红细菌的培养条件与注意事项及打管说明!
荚膜红细菌是Rhodobacter属的微生物,原产地为中国。...

类球红细菌——用于辅酶分析的标准菌株
类球红细菌是中国农业科学网收藏的一种非模式菌株。主要用于分类...